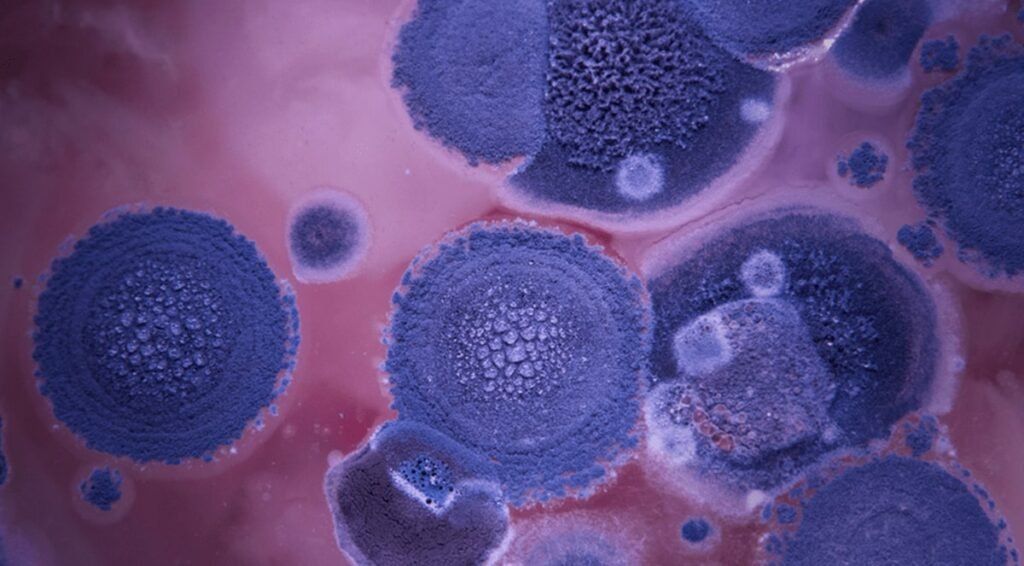

Gümüş yaprak hastalığı, armuttan ormangülüne kadar çeşitli bitkiler için tam bir felaket. Yaprakları ve dalları enfekte eden, hızlı bir şekilde tedavi edilmezse bitki için ölümcül olabilen Chondrostereum purpureum mantarının bir insana bulaştığı tespit edildi.
61 yaşındaki Hintli bir mikoloğun (mantar üzerinde araştırma yapan bilim insanı) oldukça ciddi bir gümüş yaprak hastalığına yakalandığı tespit edildi. Böylece türünün bildirilen ilk vakası, bir patojenin canlı taksonomisindeki âlemler arasında muazzam bir sıçramasının nadir bir örneğini sundu.
Laboratuvar testleri, endişe verici herhangi bir bakteri bulamadı ancak mantarlar için özel bir boyama tekniği, “hif” adı verilen uzun, kök benzeri iplikçiklerin varlığını ortaya çıkardı.
Mantar enfeksiyonları insan hayatı için önemli bir risk oluşturur. Çünkü mantar ve hayvan biyokimyasındaki benzerlikler, enfeksiyonu önleyebilen uygun aşıların ve tedavilerin tasarımını zorlaştırır.
Bazen, özellikle bağışıklık sistemi zayıf olan kişilerde, Aspergillus türleri gibi genellikle çürüyen bitkilerle beslenen mantarlar vücudumuzun daha derin kısımlarını enfekte edebilir. Fakat bu enfeksiyon diğerlerinin hiçbirine pek benzemiyor. Bu yüzden tıp uzmanları, beklenmedik patojeni DNA’sından tanımlayabilen Dünya Sağlık Örgütü Mantar Referans ve Araştırma Merkezine başvurdu.
Hasta mikolog olmasına rağmen yakın zamanda bu özel türle çalıştığını hatırlamıyordu. Ancak saha çalışması, onun çürüyen materyaller ve diğer bitki mantarlarıyla temas etmesine sebep oldu ve bu, enfeksiyonunun potansiyel olarak kaynağını oluşturdu.
Bu vaka çalışmasındaki hastanın bağışıklık sistemini baskılayıcı ilaçlar kullandığına ya da herhangi bir kronik hastalığı olduğuna dair hiçbir belirti olmaksızın tamamen işleyen bir bağışıklık sistemine sahip olduğu gerçeği, durumu daha da şaşırtıcı hâle getiriyor. Son derece nadir olmasına rağmen var olabilme potansiyeli, dikkatleri bu alana yönlendiriyor.
Derleyen: Nazlıcan Vatansever


